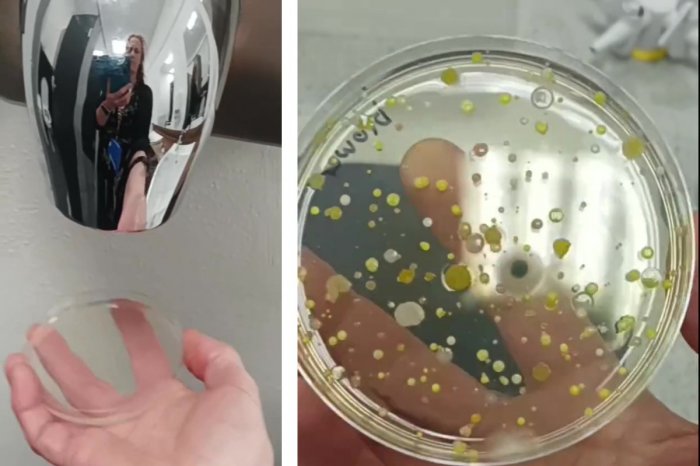
Ilustračný obrázok k článku NECHUTNÉ výsledky pokusu: Vedkyňa ukázala, prečo NEPOUŽÍVAŤ sušiče rúk na toaletách

NECHUTNÉ výsledky pokusu: Vedkyňa ukázala, prečo NEPOUŽÍVAŤ sušiče rúk na toaletách
Používate sušiče rúk na verejných toaletách? Po tomto už zaručene nebudete!
Britská vedkyňa na sociálnych sieťach zverejnila experiment, ktorý sa okamžite stal internetovým hitom. Ako informuje CNN Prima News, Ruth MacLarenová zo spoločnosti Devon Science sa zamerala na sušiče rúk na verejných toaletách.
A z jej pokusu je jasné, že spôsobujú viac škôd ako úžitku.
Radí, aby ste namiesto elektronických sušičov radšej siahli po papierových utierkach.
Čo odhalila?
Na videu ukazuje, ako pod sušič umiestnila Petriho misku. Na ňu potom nechala prúdiť vzduch z prístroja. Ako druhú vzorku použila misku, na ktorú pôsobil vzduch z jej laboratória. Obe vzorky potom na noc uložila na kultiváciu. A rozdiely? Tie boli neuveriteľné!
„Miska so vzduchom z laboratória zostala úplne čistá. Na nádobe, ktorú predchádzajúci deň vedkyňa dala pod sušič, sa však objavilo množstvo rôzne veľkých kolónií húb a baktérií,“ píše server. A práve to je dôvod, prečo vedkyňa vôbec nepoužíva sušiče rúk. Pôvodné videá pokusu si na rôznych sociálnych sieťach pozreli milióny ľudí a majú stovky tisíc reakcií.
Odkiaľ sa tam berú?
Odpoveď na otázku, odkiaľ sa vo vzduchu sušiča berú baktérie, sa napokon ukrývala vo vstupných nasávacích otvoroch prístroja. Vedkyňa z nich odobrala vzorky a vytiahla tyčinku čiernu od špiny. "Teraz už viem, kde sa baktérie v prístrojoch berú, žijú priamo v sušičoch,“ vraví.
V ďalšom pokuse sa zamerala na papierové utierky z verejných toaliet. Aj keď aj na nich vykultivovala niekoľko kolónií húb a baktérií, výsledky boli oveľa lepšie ako v prípade sušičov.
Ďalšie správy z domova i zo sveta nájdete aj na Dnes24, Facebooku a Instagrame.